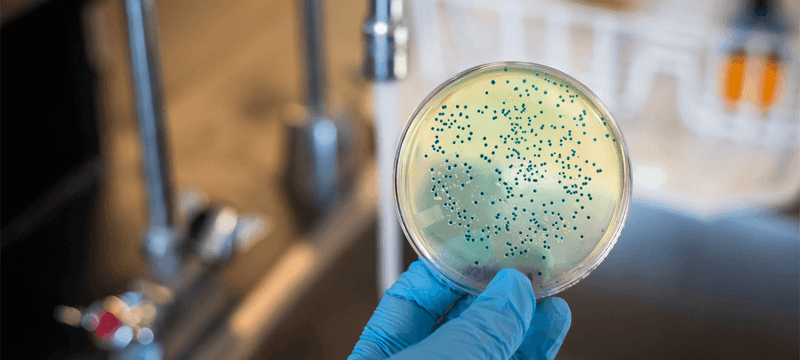

Dentro de nuestro portafolio de productos contamos con diversas soluciones para aplicaciones fisicoquímicas, desde tratamiento de muestra para determinación de sustancias orgánicas e inorgánicas, incluyendo diversos estándares hasta accesorios para diversos tipos de equipos de laboratorio.


Es fundamental la preparación eficaz de las muestras para realizar cualquier análisis químico de manera precisa y eficiente. Nuestras aplicaciones incluyen artículos, protocolos y guías de resolución de problemas en preparación de muestras. En algunas de ellas se explica cómo utilizar un producto concreto, mientras que otras se concentran en analitos o matrices puntuales. Muchas son completas guías paso a paso para la purificación de un analito específico de una matriz específica utilizando un producto específico. Además, muchas de ellas contienen instrucciones añadidas para el análisis mediante GC, HPLC, LC-MS y una variedad de otras técnicas analíticas.

Ya necesite separar y concentrar proteínas y otras biomoléculas o recoger y eliminar contaminantes de muestras de aire o líquido antes de los análisis consecutivos, nuestra amplia selección de filtros de jeringa, membranas, portafiltros y unidades de filtración para centrífuga y de flujo tangencial garantiza que contamos con la solución adecuada para su aplicación. Nuestros productos de filtración comprobados en el tiempo se han probado en los procedimientos de HPLC, espectrometría de masas, preparación de proteínas, laboratorio de análisis y control de calidad farmacéutica. Nuestros productos abarcan toda la gama de fungibles y equipos escalables para investigación, desarrollo de procesos, medio ambiente y fabricación comercial.

La extracción en fase sólida así como la micro-extracción en fase sólida son técnicas de tratamiento de muestra muy versátiles, tanto para la eliminación de interferencias, compatibilización de muestras con sistemas analíticos y concentración de muestras. Con alternativas para ensayos orgánicos e inorgánicos, nuestro amplio portafolio incluye soluciones para diversas aplicaciones, tanto para investigación, desarrollo y control de calidad rutinario.

La extracción líquido-líquido (LLE) clásica que utiliza un embudo de separación a menudo se asocia con ciertas desventajas: formación de emulsión, mala separación de fases, alto consumo de solvente, bajo grado de automatización y altos costos de personal. EXtrelut® NT simplifica la extracción líquido-líquido reemplazando los embudos de separación. El uso de un solo paso es más eficiente y proporciona ahorros de solvente, material y tiempo en comparación con la separación de embudo clásica.

El método QuEChERS, desarrollado en 2001 por Michelangelo Anastassiades consiste en un método de tratamiento de muestra muy versátil que mezcla las ventajas de la extracción sólido-líquido y líquido-líquido. Dentro de nuestras soluciones, contamos tanto con sistemas preparados como con componentes de manera individual para que sean preparados in-situ.

Nuestra amplia selección de columnas de HPLC para análisis de moléculas grandes y pequeñas le permite mejorar el proceso de separación en lo relativo a retención, resolución, selectividad y tiempo de análisis, todo ello a la vez que se reduce el tiempo de desarrollo del método

La cromatografía de gases (GC) es una técnica cromatográfica utilizada para la separación rápida de compuestos volátiles utilizando un gas portador inerte (fase móvil). La fase móvil impulsa los compuestos gaseosos a través de la columna calentada que está recubierta con una fase estacionaria sólida o líquida. Las diferencias en las propiedades químicas y físicas de los compuestos vaporizados y sus interacciones con la fase estacionaria son la base del proceso de separación.

La cromatografía en capa fina (TLC) es una técnica de separación ampliamente utilizada para análisis cuantitativos y cualitativos. Se utiliza una fina capa de una fase estacionaria que recubre una placa de vidrio, plástico o aluminio. Un disolvente líquido, denominado fase móvil, transporta la muestra y la va separando a medida que atraviesa la placa. Ofrece las ventajas de simplicidad, sensibilidad y análisis rápido con respecto a otras técnicas de separación.

Los materiales de referencia para AAS e ICP son disoluciones listas para usar, certificadas y conformes al material de referencia patrón primario del NIST. Nuestra exhaustiva documentación contiene cálculos de incertidumbre adecuados en el certificado de análisis emitido de acuerdo con las directrices de la Guía ISO 31.Nuestras disoluciones patrón de materiales de referencia certificados de uno y varios elementos TraceCERT® y Certipur® para ICP y AAS se producen utilizando material de partida de la máxima pureza, que cumple las directrices ISO/IEC 17025 e ISO 17034

Ofrecemos un amplio espectro de materiales de referencia certificados (CRM) y patrones de referencia para aplicaciones de análisis cromatográficos como análisis toxicológicos criminalísticos y clínicos, pruebas de diagnóstico, control terapéutico de medicamentos, pruebas de cannabis, análisis medioambientales, investigación farmacéutica y pruebas de alimentos y bebidas. Nuestra familia de CRM Supelco® se fabrica y prueba bajo la doble acreditación de ISO 17034 e ISO/IEC 17025, el mayor logro del sistema de calidad para los productores de materiales de referencia.

Los análisis fotométricos con el sistema Spectroquant® incluyen instrumentos, preparación guiada de muestras, una completa gama de kits de análisis fáciles de usar y un aseguramiento de la calidad analítica integral. El análisis in situ rápido requiere equipos, reactivos y kits que se transportan y utilizan fácilmente en terreno. Nuestra selección de productos portátiles de laboratorio, como nuestro reflectómetro RQflex® 20 para el control de procesos, las tiras reactivas MQuant® para análisis rápidos y los sistemas de análisis colorimétricos y volumétricos MQuant® , proporcionan resultados rápidos y económicos. Independientemente de su aplicación, nuestros instrumentos móviles, kits y tiras reactivas le proporcionarán rápidamente la precisión que necesita.
Nuestra cartera de productos de purificación de agua de laboratorio incluye sistemas de producción de agua purificada de laboratorio (agua de ósmosis inversa y de tipo II) y de agua ultrapura (tipo I) diseñados para científicos en entornos validados y no validados. Dichos entornos abarcan los laboratorios farmacéuticos, clínicos, académicos, industriales, de investigación y gubernamentales. Los sistemas Milli-Q® producen agua purificada de gran calidad para respaldar con fiabilidad sus aplicaciones específicas, abastecer sus equipos e instrumentos, y para uso general en laboratorio. Contamos con una gran diversidad de opciones de acuerdo a sus necesidades, para trabajar a partir de agua potable o pura para producir agua tipo I, II y III, ya sea individualmente o en combinaciones, con diversos grados de documentación asociada.

Ofrecemos insumos para la producción y control de calidad de sus productos.Control de calidad, Estándares, Solventes para extracción de cannabinoides, Cultivo in vitro, Fitohormonas y reguladores de crecimiento, THC, CBD, delta 9, agua, Microbiología, terpenos.

El monitoreo de la higiene es un paso crítico en las plantas de producción de alimentos y otras industrias y mercados para minimizar el riesgo de contaminación de los productos y el personal dentro de los entornos aplicables. Esto se logra mediante la verificación rutinaria de la efectividad de las prácticas de limpieza y desinfección para el equipo, el personal y las superficies de alto contacto.

Medios de cultivo deshidratados en polvo o granulados. Medios de cultivo selectivos, medios de cultivo para hongos y bacterias. Caldos y Agares, suplementos.

Ofrecemos la solución completa para la filtración microbiológica, bomba, tren de filtración, embudos, pinza y membranas estériles.

Las pruebas de esterilidad son una parte esencial de la validación de productos fabricados de acuerdo con GMP que pretenden ser estériles. Los resultados falsos negativos podrían conducir a la liberación de productos contaminados, mientras que los falsos positivos podrían dar lugar a investigaciones largas y costosas.

Las pruebas de esterilidad son una parte esencial de la validación de productos fabricados de acuerdo con GMP que pretenden ser estériles. Los resultados falsos negativos podrían conducir a la liberación de productos contaminados, mientras que los falsos positivos podrían dar lugar a investigaciones largas y costosas.

Ofrecemos variedad de equipos para microbiología de la marca INTERSCIENCES.
Ofrecemos insumos para filtración microbiológica de nuestra representada CYTIVA.
Para manejo de líquidos, ofrecemos de nuestra representada Brand.
Ofrecemos múltiples soluciones para el manejo de líquidos en el laboratorio de nuestra representada BRAND.

Rellena el formulario o comunicate por las siguientes vias:
Rellena el formulario o comunicate por las siguientes vias: